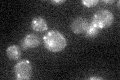
YBL098W

View description
Kynurenine 3-mono oxygenase, required for the de novo biosynthesis of NAD from tryptophan via kynurenine; expression regulated by Hst1p; putative therapeutic target for Huntington disease
Localization:
Intensity:
Fold change:
Significance:
-
C’ GFP library in SD
mitochondria21.18 -
N' NOP1pr-GFP in SD

mitochondria215.767 -
N' TEF2pr-mCherry in SD

punctate,mitochondria243.107 -
N' NATIVEpr-GFP in SD

punctate,mitochondria74.3946 -
N' TEF2pr-VC and Cyto-VN in SD

mitochondria70.8615 -
C’ GFP library in SD+DTT

mitochondria26.221.23No -
C’ GFP library in SD+H2O2

mitochondria22.51.06No -
C’ GFP library in Starvation Media

mitochondria15.60.73Yes -
C’ GFP library on the background of Pup2-DaMP

mitochondria -
C’ GFP library on the background of CCT mutant

mitochondria22.3861.0563No
